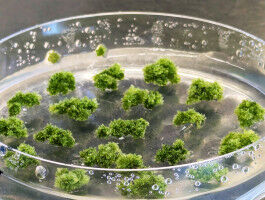
Hornworts provide clues to plant evolution

news
University of Göttingen
Results 41 - 60 of 324.
Chemistry - 03.03.2025

Research team gains new insights into the sense of hearing Hearing begins with the stretching of elastic molecular "springs" that open ion channels in the sensory hair cells of the ear. For decades, researchers have known that these gating springs must exist, but they could not find them. A team from the Cluster of Excellence Multiscale Bioimaging (MBExC) in Göttingen has now discovered just such a spring for the first time.
Computer Science - Life Sciences - 20.02.2025

International research team led by Göttingen University develops user-friendly software method Identifying and delineating cell structures in microscopy images is crucial for understanding the complex processes of life. This task is called "segmentation" and it enables a range of applications, such as analysing the reaction of cells to drug treatments, or comparing cell structures in different genotypes.
History & Archeology - 10.02.2025

Researchers analyse traces of manipulation of human remains from Maszycka Cave An international research team including the University of Göttingen has gained new insights into the burial rituals of Late Ice Age societies in Central Europe. Signs of human remains from the Maszycka Cave in southern Poland being manipulated indicate systematic dissection of the deceased, as well as cannibalism.
Environment - 30.01.2025

International research team shows benefits of cacao grafting for farmers and nature alike The productivity of cacao trees decreases with time, forcing farmers to renew their plantations by either cutting down the old trees or establishing a new crop elsewhere. Frequently, new plantations are established in areas of the forest that are thinned out to accommodate new, young cacao trees.
Physics - 29.01.2025

International research team led by Göttingen University develops new method for ultrafast imaging of dark excitons How can the latest technology, such as solar cells, be improved? An international research team led by the University of Göttingen is helping to find answers to questions like this with a new technique.
Earth Sciences - 28.01.2025

Research team investigates influence of Zagros Mountains on bending Earth's surface An international research team led by the University of Göttingen has investigated the influence of the forces exerted by the Zagros Mountains in the Kurdistan region of Iraq on how much the surface of the Earth has bent over the last 20 million years.
Astronomy & Space - Earth Sciences - 21.01.2025

International research team measures extreme winds on an exoplanet An international research team led by the University of Göttingen has discovered extremely strong winds on the exoplanet "WASP-127b". The winds along the equator of this planet can reach speeds of up to 33,000 kilometres per hour. These results help better understand the atmosphere of planets outside our solar system.
Astronomy & Space - Environment - 21.01.2025

International research team measures extreme winds on an exoplanet . An international research team led by the University of Göttingen has discovered extremely strong winds on the exoplanet "WASP-127b". The winds along the equator of this planet can reach speeds of up to 33,000 kilometers per hour. The results of the research help to better understand the atmosphere of planets outside our solar system.
Life Sciences - Environment - 20.01.2025
Researchers create dataset resource to understand plant development, resilience and biodiversity Land plants are extremely diverse: over 400,000 species reaching every corner of the world. This diversity mainly splits into two plant lineages: vascular and non-vascular. Vascular plants are the ones that often capture our attention - from the towering trees to the crops in our fields.
Astronomy & Space - Earth Sciences - 15.01.2025

Researchers from Göttingen in Germany shed new light on the formation of the Moon and origin of water on Earth A research team from the University of Göttingen and the Max Planck Institute for Solar System Research (MPS) has discovered another piece in the puzzle of the formation of the Moon and water on Earth.
Environment - 14.01.2025

Research team emphasize global importance for biodiversity, economy and climate Tree crops - for example, apple, cherry, olives, nuts, coffee, and cacao - cover more than 183 million hectares worldwide, yet remain largely overlooked in agricultural policies, despite their critical role in achieving the United Nation's Sustainable Development Goals (SDGs).
Earth Sciences - Environment - 08.01.2025

International research team achieve first precise tracking of undersea sand and mud avalanche How do large mud and sand currents influence the deep-sea habitat? And how can they be better understood? An international research team led by Durham University, UK, and including the University of Göttingen and GEOMAR Kiel, Germany, investigated further.
Environment - 04.12.2024

Connectivity and maintenance measures support wild bees in limestone quarries A research team at the University of Göttingen, Germany's Nature And Biodiversity Conservation Union (NABU) in Rhede, and the Thünen Institute in Braunschweig has investigated the importance of limestone quarries for wild bee conservation.
Environment - 28.11.2024

Research team led by Göttingen University studies carbon movement from tree to root fungi The idea of trees "talking" to one another through underground fungal networks - the so-called "wood wide web" - has captured the imagination of the public. This concept, where trees supposedly share nutrients with each other via these networks, has been popularized by books and documentaries.
Environment - 28.11.2024

Research team led by the University of Göttingen investigates carbon transport from the tree to the root fungus The idea that trees "communicate" with each other via underground fungal networks - the so-called "Wood Wide Web" - has captured the imagination of many people. Books and documentaries have popularized the concept of trees supposedly exchanging nutrients with each other through these networks.
Environment - Agronomy & Food Science - 21.11.2024

International research team led by Göttingen University define optimal shade trees in agroforestry Agroforestry systems, which integrate trees and shrubs into farming, are vital to achieving sustainable cocoa production in West Africa where 70 percent of the world cocoa is produced. Climate change induced drought means that it is ever more critical to adapt farming practices and find new approaches.
Environment - 15.11.2024

Research team led by Göttingen University investigate native species recovery in Sumatra Southeast Asia's tropical forests are renowned for their biodiversity, but at the same time face significant threats from the expansion of oil palm plantations. With global demand for palm oil rising, the urgency for effective restoration strategies in these landscapes has become critical.
Environment - 13.11.2024

Research team analyse biodiversity, ecosystems and economics of enriching beech forests with conifers Forests provide biodiversity, ecosystem functions, income and much more. How can these diverse and seemingly diverging demands be met? An international research team led by the University of Göttingen addressed this question by analysing the effects of enriching beech forests in Germany with commercially valuable native (to mountainous regions of Europe) and non-native conifer species, in this case, the Norway spruce and Douglas fir, respectively.
Environment - Agronomy & Food Science - 05.11.2024

International research team investigates sustainable increase in macadamia nut production An international research team led by the Universities of Göttingen and Hohenheim has gained new insights into how the interaction between bees, bats and birds significantly increases the quantity and quality of macadamia nuts.
Environment - Agronomy & Food Science - 05.11.2024

International research team finds pollinators and predators promote profitable, sustainable farming An international research team led by the universities of Göttingen and Hohenheim in Germany has gained new insights into how the interaction of birds, bees and bats significantly increases the quantity and quality of macadamia nuts.
Computer Science - Mar 20
New computer chip material inspired by the human brain could slash AI energy use
New computer chip material inspired by the human brain could slash AI energy use

Politics - Mar 20
Argentina 50 years on from start of dictatorship - is it forgetting the disappeared?
Argentina 50 years on from start of dictatorship - is it forgetting the disappeared?
Life Sciences - Mar 20
Courting the Competition: Some Male Fruit Flies Serenade Each Other Rather Than Fight
Courting the Competition: Some Male Fruit Flies Serenade Each Other Rather Than Fight

Social Sciences - Mar 20
Louis Theroux's manosphere documentary shows some of the subtle ways we can undermine online misogyny
Louis Theroux's manosphere documentary shows some of the subtle ways we can undermine online misogyny

Life Sciences - Mar 20
Hidden Helpers: Pittsburgh's Industrial Past Might Hold the Key to a Cleaner Future
Hidden Helpers: Pittsburgh's Industrial Past Might Hold the Key to a Cleaner Future
Pharmacology - Mar 19
GSK, University of Oxford and Imperial College London launch centre to create computer models of lungs, liver, kidneys and cartilage
GSK, University of Oxford and Imperial College London launch centre to create computer models of lungs, liver, kidneys and cartilage

Innovation - Mar 19
India's new wave of Hindu Religious Entrepreneurship is reshaping our interpretation of success
India's new wave of Hindu Religious Entrepreneurship is reshaping our interpretation of success
Pharmacology - Mar 19
Oxford University spinout Dark Blue Therapeutics acquired to advance leukaemia treatment
Oxford University spinout Dark Blue Therapeutics acquired to advance leukaemia treatment
Veterinary - Mar 19
New RVC study challenges common beliefs on desirable behaviours in designer 'Doodle' crossbreeds
New RVC study challenges common beliefs on desirable behaviours in designer 'Doodle' crossbreeds

Agronomy & Food Science - Mar 19
Bird Flu Risk to Danish Cattle - New Tool Can Warn Farmers Before Infection Spreads
Bird Flu Risk to Danish Cattle - New Tool Can Warn Farmers Before Infection Spreads









